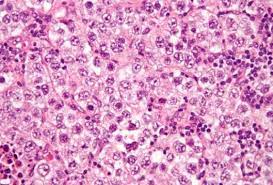
Consecuencias de la criptoorquidia

La criptorquidia, o testículo no descendido, es una afección en la que uno o ambos testículos no completan su migración desde el abdomen hasta el escroto durante el desarrollo fetal. Esta condición puede tener consecuencias graves en la salud a largo plazo, incluidas alteraciones histológicas irreversibles en el testículo y un aumento en el riesgo de padecer cáncer testicular.
Alteraciones histológicas irreversibles en el testículo
El proceso de descenso testicular es fundamental para el desarrollo normal del testículo. Los testículos descienden del abdomen hacia el escroto debido a una combinación de factores hormonales y mecánicos. Cuando este proceso se interrumpe debido a la criptorquidia, los testículos pueden permanecer en el abdomen, en el canal inguinal o en la región inguinal.
La temperatura es un factor crucial para el desarrollo y la función adecuada de los testículos. Los testículos necesitan mantener una temperatura ligeramente más baja que la temperatura corporal para producir espermatozoides de manera eficiente. El escroto, que está fuera del cuerpo, proporciona el ambiente adecuado para esta temperatura más baja.
Cuando un testículo no desciende al escroto, su temperatura puede aumentar debido al calor del cuerpo. Esto puede afectar negativamente la función de las células germinales (las células que producen los espermatozoides) en el testículo y resultar en alteraciones histológicas irreversibles. Estas alteraciones pueden incluir:
- Degeneración testicular: Las células germinales pueden sufrir degeneración y daño, lo que puede afectar la producción de espermatozoides. Esto puede llevar a una disminución en la producción de espermatozoides o a la producción de espermatozoides de calidad inferior.
- Atrofia testicular: La atrofia testicular se refiere a una reducción en el tamaño y el peso del testículo. Puede ser el resultado de la degeneración de las células germinales y otros cambios en el tejido testicular. La atrofia testicular puede afectar aún más la función y la producción de espermatozoides.
- Fibrosis: La fibrosis es la formación excesiva de tejido cicatricial en el testículo. La presencia de fibrosis puede afectar negativamente la función testicular y la producción de espermatozoides.
Aumento del riesgo de cáncer testicular
Varios estudios han demostrado que los individuos con criptorquidia tienen un mayor riesgo de desarrollar cáncer testicular en comparación con aquellos cuyos testículos han descendido normalmente. La razón detrás de esta asociación no está completamente clara, pero se cree que los cambios histológicos y la alteración del entorno testicular debido a la criptorquidia pueden contribuir al aumento del riesgo de cáncer testicular. Algunos posibles mecanismos incluyen:
- Disrupción del desarrollo: La criptorquidia interrumpe el desarrollo normal del testículo y puede dar lugar a anomalías genéticas o epigenéticas que predisponen al cáncer.
- Cambios en el microambiente: La temperatura elevada en el abdomen o el canal inguinal puede afectar el microambiente testicular, creando condiciones que favorecen el desarrollo de células cancerosas.
- Mayor vulnerabilidad: Las alteraciones histológicas y la disminución de la función testicular pueden dejar el tejido más vulnerable a los factores carcinogénicos.

Síguenos en X: @el_homomedicus y @enarm_intensivo Síguenos en instagram: homomedicus y en Treads.net como: Homomedicus